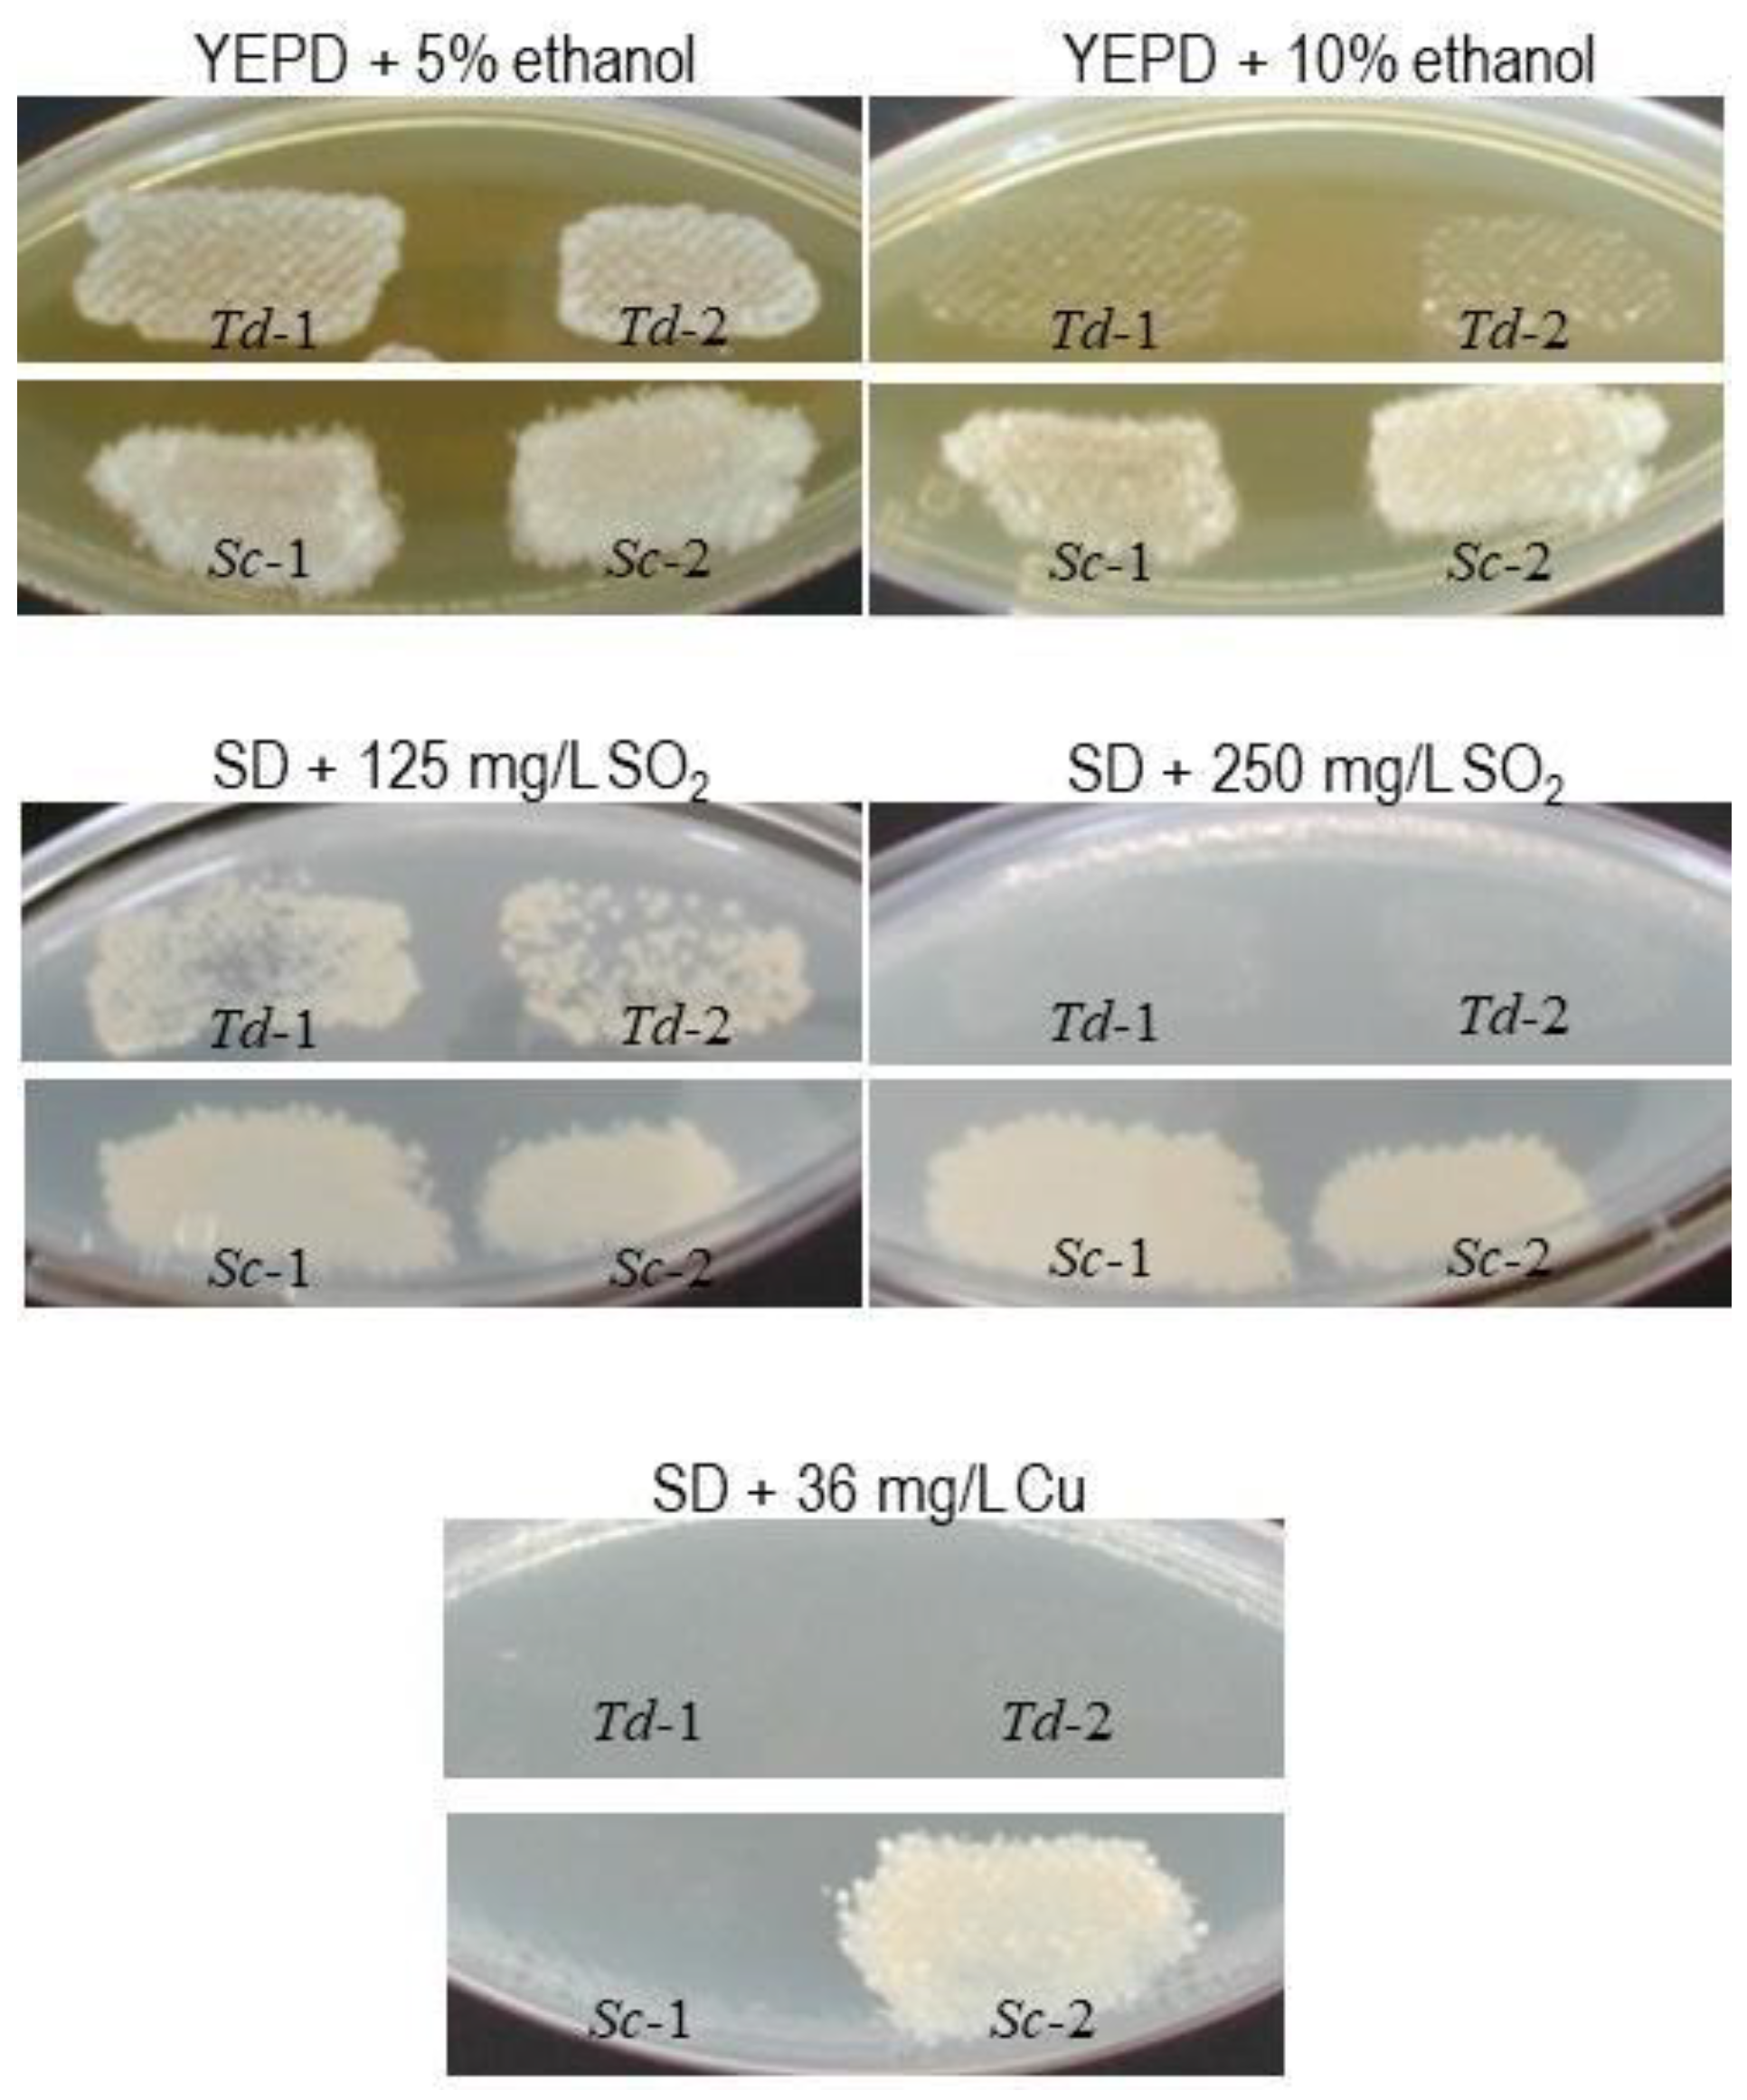
Fermentation 04 00094 g002

2. The Torulaspora Yeasts
Torulaspora are fermentative yeasts that can be found in wild and anthropic habitats, where they may coincide with other fermentative yeasts such as
Saccharomyces and
Zygosaccharomyces. In the past, there has been some misclassification of some species in these three genera, because they share various morphological and physiological features. The genus
Torulaspora includes at least six species:
T. delbrueckii (anamorph
Candida colliculosa),
T. franciscae,
T. pretoriensis,
T. microellipsoides,
T. globosa, and
T. maleeae [
2]. Other species have also been proposed for inclusion in this genus following their characterisation by molecular tools used to discriminate new isolates, examples being
T. indica [
3] and
T. quercuum [
4]. The taxonomy of
Torulaspora is changing rapidly, and one can expect species reassignments and new species in the near future. In this sense, based on the nucleotide sequence of the internal transcribed spacer (ITS) region located between the 18S and 28S rRNA genes, it has already been proposed that
Zygosaccharomyces mrakii and
Z. microellipsoides might be reclassified in the genus
Torulaspora [
5]. Similarly, four strains presumed to be
T. delbrueckii were found to be considerably different from the type strain, and were reclassified into the genera
Debaryomyces and
Saccharomyces [
6]. In particular, one must bear in mind that some error in the presumptive assignment of a new isolate to
Torulaspora may explain some of the controversial results found for the biotechnological properties that have been recently claimed for these yeasts (see
Section 5 below).
Torulaspora cells mostly have a spherical shape (
torulu), although ovoid and ellipsoidal shapes are also frequent. Its cellular size, 2–6 × 3–7 µm, uses to be smaller than that of
S. cerevisiae (
Figure 1A,E).
Torulaspora may rarely produce pseudohyphae, but never true hyphae. Its life cycle has yet to be elucidated. In contrast with wild
S. cerevisiae strains, which are diploids or polyploids during vegetative propagation,
T. delbrueckii was long believed to be a haploid yeast, mainly because of its small cell size [
7], and because tetrads are absent or rarely observed in sporulation media. However, it has recently been suggested that
T. delbrueckii may actually be mostly diploid and homothallic [
8]. If this is the case, the small cell size of
Torulaspora may still be explained by its having only 16 chromosomes in the diploid stage, instead of the 32 chromosomes that are present in
S. cerevisiae diploid yeasts. It is believed that
T. delbrueckii diverged from the
S. cerevisiae lineage before the latter underwent its genome polyploidisation [
9].
All species of
Torulaspora reproduce asexually by multilateral budding (mitosis). Sexual reproduction may occur in sporulation media through asci that contain one to four spherical ascospores (
Figure 1B). The ascus can be originated by the heterogamic conjugation between a cell and its bud, or between two independent cells. Three types of conjugation have been proposed in the
Torulaspora genus [
10]: (i) between mother and daughter cells (the daughter cell may be one small bud still attached to the mother cell, but separated from it by a cross-wall); (ii) between two cells with their respective conjugation tubes; and (iii) between a cell with conjugation tube and another cell without it. The ascospores (one to four per ascus, frequently two, 2–4 μm diameter) are spherical with a smooth or warty cell wall. It should be noted that starvation is not required for
T. delbrueckii to sporulate [
8,
11]; i.e., spores can be formed on rich media such as yeast extract peptone dextrose (YEPD) agar (
Figure 1D), as also may occur for some wine strains of
S. cerevisiae.
Cells with conjugation tubes are frequent in
T. delbrueckii, mainly in non-growing cells in a stationary growth stage or in sporulation media (
Figure 1B), but most of them seem uninvolved in the yeast conjugation process [
12]. Probably, most of the several buds that have been frequently observed in single non-growing yeasts are actually incipient cell wall protuberances destined to potentially become a conjugation tube for yeast mating.
Given this lack of precise knowledge about the life cycle of
Torulaspora, it is complicated to design strategies for the biotechnological improvement of
T. delbrueckii by using classical genetic techniques such as those proposed for
S. cerevisiae wine yeasts [
13,
14,
15,
16].
3. Growth and Fermentation Capability
With respect to the features required to perform industrial alcoholic fermentation, of the non-
Saccharomyces yeasts,
T. delbrueckii is the most similar to the referent, best-considered,
S. cerevisiae. This is the main reason why
T. delbrueckii was the first non-
Saccharomyces yeast proposed for industrial use in wine fermentation [
17]. However, slight but relevant differences in the physiological characteristics of the two yeasts affect their choice as options for different industrial applications. In particular, the specific rates of CO
2 production and O
2 consumption are higher in
T. delbrueckii than in
S. cerevisiae, which results in lower biomass yields from batch cultures, and may represent a handicap for the large-scale production of
T. delbrueckii with respect to
S. cerevisiae [
18]. The two yeasts’ sugar utilisation and regulation patterns are very similar, with similar biomass yields in glucose-limited oxygen-sufficient chemostat cultures, as is consistent with fully respiratory growth. Interestingly,
S. cerevisiae is the first to switch to a respirofermentative metabolism as the oxygen feed rate decreases, showing a lower biomass yield at low oxygen tensions with respect to
T. delbrueckii, which is still able to sustain full respiration under these conditions [
19]. Unfortunately, however,
T. delbrueckii shows less growth than
S. cerevisiae under strict anaerobic conditions [
20,
21], and has less fermentation vigour and slower growth rate than
S. cerevisiae under usual wine fermentation conditions, being quickly overcome by wild or inoculated
S. cerevisiae strains [
18,
22]. Obviously, this is an important issue for winemaking, which is usually done under strict anaerobic conditions for white and sparkling wines, or in the presence of very low amounts of oxygen for red wines, where the cap of grape skins is punched down into the must several times a day. A poorer performance of
T. delbrueckii with respect to
S. cerevisiae should always be expected under these working conditions, especially for white and sparkling wines.
When inoculated in fresh grape must, the dominance ratio of
T. delbrueckii depends on many factors: the size of the inoculum, amount and types of viable wild microbes initially present in the must, fermentation stage, sugar and ethanol concentrations, killer phenotype and killer sensitivity of the inoculated yeast and the wild yeasts, SO
2 (sulfur dioxide) concentration, Cu (copper) concentration, pesticides coming in with the grapes, etc. Some of these have been analysed in several related works. The
T. delbrueckii dominance ratio during the must fermentation reported in the literature of specialised research works ranges from 0 to 100%, being in most cases around 50% in tumultuous fermentation [
22,
23,
24,
25,
26,
27]. This dominance ratio can be expected to be lower in commercial wineries, where the working conditions are not as controlled as in research laboratories or experimental wineries. This ratio is much lower than that which is expected for the reference yeast
S. cerevisiae, which is assumed to be close to 100%, even considering that this yeast is usually inoculated at a lower concentration (around 10
6 CFU/mL) than
T. delbrueckii (around 10
7 CFU/mL).
A strong dominance of
T. delbrueckii is usually achieved by using sterile or much clarified must, and a killer strain for inoculation. In this way, the relative initial growth of the
T. delbrueckii population is high, and favours its becoming the clear protagonist during fermentation. Nonetheless, since this yeast is less resistant than
S. cerevisiae to high ethanol concentrations (
Figure 2), the fermentation rate slows down, and cell death increases after the tumultuous fermentation of sugar-rich musts (Figure 4). As a consequence, fermentation may stop, slow down and become sluggish, or continue mainly because of the presence of some contaminating wild
Saccharomyces yeasts, which may continue must fermentation if the required nutrients are still available. Obviously, any such sequence of events will reduce the domination ratio of
T. delbrueckii by the end of fermentation, even down to its disappearance [
22,
24]. This situation is more evident and occurs more rapidly when mixed-inoculating with the two yeasts (co-inoculation or sequential inoculation) in grape must be supplemented with yeast nutrients. In this case, the dominance of
T. delbrueckii, if it occurs at all, is usually ephemeral, lasting no more than two days [
18,
22,
24].
This situation makes it difficult to reliably assign a specific feature to
T. delbrueckii, and may explain why some disagreement is found in the literature about the effect of this yeast on winemaking and wine quality. For example, the effects related to the production of some aroma compounds remain confusing. Mixed
T. delbrueckii/
S. cerevisiae inoculation has been described as increasing the total ester concentration (mainly isoamyl acetate and ethyl hexanoate, octanoate, and 3-hydroxybutanoate) relative to inoculation with
S. cerevisiae [
28], while the contrary has also been reported [
29,
30]. Such contradictory results may occur just because the production and degradation of these compounds depend on the proportion of each species of yeast during must fermentation. Likewise, even when a putative technological improvement of
T. delbrueckii affecting the quality of wine has been accepted, it is still very complicated to achieve the desired result in commercial wineries if the dominance of this yeast cannot be ensured, and this may dissuade œnologists from spending money purchasing new non-
Saccharomyces yeasts for must inoculation. Consequently, it is necessary to thoroughly control the level of dominance of
T. delbrueckii throughout the wine fermentation process, analysing adequate numbers of samples and colonies of viable microorganisms sampled at different times during that process. Frequently, one finds in the literature that few samples and yeast colonies were analysed (10 colonies, only twice per fermentation [
31]), or simply that the inoculated
T. delbrueckii strain was not monitored, but was simply assumed to dominate the wine fermentation [
32]. Moreover, in some cases, the authors themselves recognise the presence of contaminating yeasts in the pasteurised must; these are yeasts that, in parallel experiments in which there was no dominance of the inoculated yeast, were able to complete the fermentation. Even more so, in some cases, the fermentations were carried out by continuous mixing of the inoculated must in an orbital shaker to increase the oxygen supply [
31], contrary to what is usually done in commercial cellars where the must is not continuously agitated. Therefore, in sum, the different environmental conditions used in the experimental fermentations of
T. delbrueckii, and the uncertainty about the desired dominance of this yeast during fermentation, suggest that the observed effect of a given strain on the quality of wine may be different, or even contradictory, depending on the working conditions. Consequently, it would be necessary to establish criteria that are more precise regarding the experimental conditions and the minimum level of dominance of
T. delbrueckii in order to obtain more homogeneous and reliable conclusions about any of the advantages of this yeast in winemaking.
In the absence of general agreement on these criteria, one possibility that might explain some of the conflicting results found is that different
T. delbrueckii strains might have different fermentation capabilities. This would not be too surprising, given the possible lack of a reliable and definitive taxonomic classification. However, to confirm this argument, it would be necessary to test in parallel the different yeast strains under identical experimental conditions, and achieve a clear dominance of each strain tested. Moreover, in addition to the idea that the production of esters by
T. delbrueckii might be strain-dependent, it has been proposed that this production may even vary when this yeast is associated with
S. cerevisiae in mixed cultures [
25,
33,
34]. This situation may become even more complicated, although clearly very interesting, when considering the use of
T. delbrueckii for red winemaking, since this differs from white winemaking in certain aspects that affect this yeast’s growth during must fermentation, and hence its effect on wine quality. Namely, oxygen availability, alcohol content, the amount of initial wild microorganisms, and nutrient availability are usually greater in red than in white wine fermentation. Given these differences, and since fermentations dominated by
T. delbrueckii are slower than those dominated by
S. cerevisiae, the eventual development of lactic acid bacteria may promote malolactic fermentation occurring simultaneously with alcoholic fermentation. This promotion is enhanced in situations where these bacteria may be more frequent, as when using poorly clarified musts or crushed grapes as starting material for winemaking. Indeed, we found that in such situations all of the
T. delbrueckii wines, but none of the
S. cerevisiae wines, underwent malolactic fermentation, and putative lactic acid bacteria were always found in the
T. delbrueckii wines, but none or very few were found in the
S. cerevisiae wines. The highest malic acid degradation was found in those wines where
T. delbrueckii reached the greatest dominance ratios, and at the same time, had the slowest fermentation kinetics [
23,
24]. Likewise, some companies, such as Chr. Hansen (Hoersholm, Denmark), recommend inoculation with
T. delbrueckii to promote malolactic fermentation, although in this case, the effect is claimed to be due to a decreased production of toxic medium-chain fatty acids that favour the growth of lactic acid bacteria.
I.E., the confluence of so many environmental factors in winemaking that may change the behaviour of T. delbrueckii with respect to the production of aroma compounds makes it difficult to design a reliable strategy for wine quality improvement in commercial wineries. In any case, until the handicap of low dominance of T. delbrueckii is resolved, one cannot determine with precision the real usefulness of these yeasts in the cellar. To address this problem, further knowledge is required of how T. delbrueckii interacts with other wine microorganisms during wine fermentation so as to be able to ensure the dominance of this yeast species.
4. Interaction with Other Fermentative Yeasts and Ability to Dominate Must Fermentation
As noted above, the ability of S. cerevisiae to overcome other non-Saccharomyces yeasts and dominate wine fermentation can be explained mainly by its excellent biological fitness and its tolerance to the stress factors that converge in this process. This circumstance makes it possible that an almost undetectable contamination of S. cerevisiae in a must that has been previously inoculated with T. delbrueckii can be responsible for carrying out most of the fermentation process. This may occur because T. delbrueckii dies prematurely, or because its metabolic activity declines markedly as a result of the environmental stress. However, the opposite case is clearly unlikely, so that non-Saccharomyces yeasts usually play an irrelevant part in the fermentations of musts inoculated with S. cerevisiae. Biotechnologically, this situation will not change until T. delbrueckii strains whose biological efficacy is similar to that of S. cerevisiae are available, which is an aspect that we shall return to later in this review. Apart from this, other types of direct interactions between the two yeast species have been described that can influence, or even determine, the preponderance of one yeast over the other.
The yeast interactions in pure and mixed fermentations have been the subject of a thorough review [
35] which clearly stated that the competitiveness of any given strain can be influenced by many factors, which are both abiotic (pH, temperature, ethanol, osmotic pressure, nitrogen availability, molecular sulfur dioxide concentration, etc.) and biotic (type of microorganisms, presence of antimicrobial molecules, cell-to-cell contact, grape variety, etc.). This competitiveness will change depending on the specific environmental conditions of a given food fermentation, which will in turn influence the ability of a given strain to out-compete other yeasts. Moreover, in mixed fermentation, the choice of the specific strains of
T. delbrueckii and
S. cerevisiae can be another biotic factor to consider as an origin of variability in the competitiveness of each yeast strain. However, the use of a fixed couple of yeast strains could produce predictable results related to the dynamic of each yeast population and, thereby to the wine quality.
With respect to the biotic factors, a new wine
T. delbrueckii killer strain has recently been characterised. It secretes a killer toxin (Kbarr-1) that is encoded in a double-stranded RNA virus (ScV-Mbarr-1) with broad antifungal activity against
S. cerevisiae (killer and non-killer strains) and other non-
Saccharomyces yeasts [
36,
37]. This negative interaction has already been applied to promote the dominance of
T. delbrueckii in white [
24] and red [
23] table wines. This killer strain had the advantage of dominating must fermentation in the presence of
S. cerevisiae relative to the non-killer isogenic strains. However, full dominance is not ensured if a fairly large population of
S. cerevisiae yeasts (about 10
6 CFU/mL) is co-inoculated or was already present as wild yeasts in the grape must. Therefore, a large inoculum (about 10
7 CFU/mL) of
T. delbrueckii should be considered to achieve satisfactory dominance in these situations.
Apart from this, yeast growth inhibition by cell-to-cell contact is another biotic factor that may influence the competitiveness of each strain in multi-starter fermentations. Physical contact between
S. cerevisiae and
T. delbrueckii seems to induce the rapid death of the latter yeast. However, when the two yeasts were separated from each other in a double-compartment fermenter,
T. delbrueckii maintained its viability and metabolic activity [
38]. The details of this mechanism of cell-to-cell contact inhibition are still unknown. It has recently been proposed that in the case of the early death of
L. thermotolerans during anaerobic fermentation mixed-inoculated with
S. cerevisiae, this phenomenon is caused by a combined effect of cell-to-cell contact plus antimicrobial peptides [
39]. Similarly, it has been found that cell-free
S. cerevisiae supernatants induce fast culturability loss in other non-
Saccharomyces yeasts, meaning that this inhibitory effect is mainly caused by some metabolites secreted by
S. cerevisiae. To further complicate the issue, the culturability loss of non-
Saccharomyces yeasts induced by
S. cerevisiae is species-dependent and strain-dependent [
40]. The effect of these biotic factors on the competitiveness of each strain can be influenced by an abiotic factor, an example being the addition of assimilable nitrogen, which was found to partially mitigate the inhibitory interaction between different yeasts [
41].
Given this situation in which many different factors may influence a given yeast’s competitiveness with respect to others, and the lack of precise knowledge about the mechanisms of this influence, the degree of compatibility of co-inoculated strains of
T. delbrueckii and
S. cerevisiae must be known with precision in order to program and control the industrial use of that combination. This is especially important if a specific proportion of the fermentation must be performed by
T. delbrueckii in order to obtain a determined effect on the final wine’s organoleptic quality. Mixed inoculation results may not be fully satisfactory if the production of aromas by
T. delbrueckii varies when it is associated in a variable and difficult-to-control proportion with
S. cerevisiae, or when the type and amount of the aromas produced in mixed cultures depend on a synergistic interaction between these two yeasts [
33]. If this is the case, the use of
T. delbrueckii in mixed-inoculated fermentation could be a situation that is far too complicated to control satisfactorily at an industrial level. However, if total or major dominance of
T. delbrueckii is desired, this can be achieved using killer strains, a large yeast inoculum (approximately 10
7 CFU/mL), and grape must containing only a discrete amount of wild
Saccharomyces yeasts (less than 10
5 CFU/mL) [
23,
24,
42]. In this situation, if the effect of
T. delbrueckii on the quality of the wine is more intense than desired, this could be resolved by mixing with conventional
S. cerevisiae wine to obtain the required wine quality.
5. Influence on the Chemical Composition and Aroma of Table Wine
As mentioned in the Introduction section, several wine parameters can be improved by inoculating the must with
T. delbrueckii. However, some of these claimed improvements can be achieved only in certain specific circumstances. For example, the production of reduced amounts of acetic acid is usually found only in high-sugar fermentations, which are conditions where
S. cerevisiae produces high amounts of this compound [
43]. It is possible that no such effect will be achieved with usual sugar concentrations, because
T. delbrueckii-dominated fermentation takes a long time to complete, and this may lead to the additional oxidation of the wine [
23,
24]. Sometimes, the claimed improvement may not be very relevant; an example is the reduction in ethanol concentration, which is usually low under anaerobic conditions, and correlates with increased acetic acid and residual sugar contents [
44,
45], both of which may be undesirable. Moreover, the supposed improvement may not be generally reproducible at commercial wineries, given that contradictory results have been described in experimental vinifications, as is the case for the claimed increased amount of important aromatic compounds: fruity esters, lactones, thiols, and terpenes [
23,
24,
25,
26,
28,
29,
30,
33,
34,
46,
47].
These circumstances may result in eventual disappointment for œnologists attempting to improve some wine types, such as young white or rosé wines, by using T. delbrueckii. The T. delbrueckii wines may contain slightly greater amounts of volatile acidity and residual sugars, have roughly the same amount of ethanol, have decreased fresh fruity aromas, or be slightly oxidised with respect to S. cerevisiae wines. Considering that using T. delbrueckii for winemaking is more expensive and time consuming that using conventional S. cerevisiae yeasts, and that most of the commercially available wine strains of the latter yeast are of proven virtuosity for winemaking, most œnologists may refuse to further try T. delbrueckii to improve wine quality. Therefore, wine yeast researchers and producer firms should be very careful in advising very precisely those winemaking conditions that may really be appropriate for wine quality improvement by using T. delbrueckii, perhaps even more careful than when the original recommendations were given for inoculating with S. cerevisiae yeasts (about one century ago) to improve winemaking with respect to traditional spontaneous must fermentation. Otherwise, the use of T. delbrueckii for commercial winemaking may become just anecdotal and circumscribed to experimental research, as will probably end up being the case for many other non-conventional wine yeast species.
Given that these important prior considerations must be kept in mind, we shall now look at some specific approaches using
T. delbrueckii in terms of its most common effects on wine quality and aroma composition, and which have so far been described as being independent of the winemaking conditions. These are decreased acetic acid production in grape must with a high sugar concentration, decreased concentrations of the main esters, and increased concentrations of lactones and some minor ethyl esters, which are all relative to
S. cerevisiae-fermented wines. Overall, these effects have led to decreased fresh-fruit aroma intensity, but increased aroma complexity with a dried-fruit/pastry flavour, which is achieved mainly when the
T. delbrueckii strains reached a high dominance ratio (above 70% of viable cells) at the tumultuous fermentation stage [
23,
24,
26,
29,
30]. It should be noted that part of this effect on the aroma complexity of wine may be due to the growth of lactic acid bacteria [
23]. According to these common effects, the use of
T. delbrueckii for young (white or rosé) table wines should not be recommended mostly because of the loss of fresh-fruit aromas, which are usually wanted in these types of wine. However, an exception should be considered for those specific situations in which a low dominance ratio of
T. delbrueckii does not reduce the fresh-fruit aroma intensity of the wine, or it interacts with
S. cerevisiae to increase the amounts of specific aromas such as volatile thiols (3-sulfanylhexan-1-ol and 3-sulfanylhexyl acetate) that clearly improve the quality of certain wines, with Sauvignon Blanc being an example [
33,
48]. Besides this, we think that inoculation with
T. delbrueckii can mostly be recommended for full-bodied red wines made from grapes with undesirably high malic acid content, natural sweet wines made from grapes with high sugar content, or any aged wine in which the dried-fruit aromas and oxidised character that are usually produced by this yeast may be greatly appreciated by the consumers.
6. Traditional Sparkling Wine Making
There have also recently been trials of the use of
T. delbrueckii for sparkling wine making. The sequential inoculation of this yeast with
S. cerevisiae has been shown to be an interesting tool with which to obtain base wines (first fermentation of the grape must) with different characteristics [
22]. However, those authors did not analyse the usefulness of
T. delbrueckii to finally complete the production of sparkling wine (second fermentation of the base wine), probably because they suspected that this yeast could not complete this task. We confirmed these results in a recent work, finding that
T. delbrueckii could indeed be used to improve base wine quality, but was unable to complete second fermentation, because it cannot survive above 3.5 atm of CO
2 pressure [
49]. However, we should point out that base wine that was single-inoculated with
T. delbrueckii was able to complete second fermentation when there was a very small contamination (4.3 × 10
−5 CFU/mL) of
Saccharomyces yeasts, which became dominant by the time CO
2 pressure increased above 3 atm, and
T. delbrueckii quickly became inviable (
Figure 3). This clearly indicates that CO
2 pressure is another abiotic factor that may decrease the competitiveness of
T. delbrueckii relative to other potential competitor microorganisms such as
S. cerevisiae, and that its resistance to high pressure should be genetically improved to get a dominance of this yeast during the second fermentation of sparkling wine.
It should also be mentioned that two
T. delbrueckii strains (DiSVA 130 and DiSVA 313) single-inoculated in a base wine with high ethanol concentration (11.65% vol) were able to complete the secondary fermentation of sparkling wine even more efficiently than single-inoculated
S. cerevisiae [
32]. This was an unexpected result, mainly because there had been no previous data reported related to the resistance of these DiSVA strains at high ethanol concentrations. Whichever the case, these authors unfortunately did not confirm the dominance of the inoculated strains during second fermentation. Therefore, some contamination with
S. cerevisiae yeasts may have occurred, with these being the yeast that was actually responsible for second fermentation completion, as was the case mentioned above (
Figure 3).
7. Proposals for Genetic Improvement of T. delbrueckii
The main disadvantages of
T. delbrueckii that hinder it from becoming as good as
S. cerevisiae for industrial use are probably its small cell size [
50], slow growth rate, and low fermentation vigour under the usual alcoholic fermentation conditions [
18,
22,
24]. These peculiarities result in small harvest quantities in industrial biomass production, and extra difficulties in recovering, washing, and dehydrating the yeast biomass using conventional microfiltration, which may take a long time because the filters become clogged by the small yeast cells, and have to be replaced frequently.
The small cell size of
T. delbrueckii cells seems to be because it propagates vegetatively as a haploid yeast [
7], while the industrial strains of
S. cerevisiae propagate as diploid or polyploid yeasts. This cell size can be enlarged by increasing the number of chromosomes (ploidy) inducing diploids through perturbed protoplast regeneration or the UV irradiation of intact cells [
51,
52,
53]. Stable diploid strains have already been constructed from baker’s haploid
T. delbrueckii strains. These diploid strains were about three times larger than the original parental haploid, while both types had similar biomass yield, stress resistance, gassing power, and sweet dough-leavening ability. The propagation and manipulation of this artificially constructed diploid seemed to be enhanced under industrial conditions, and its stress tolerance and CO
2 production after direct freezing make it possible to reduce the yeast dose in the formulation of frozen sweet bakery products [
51,
53]. These interesting results for baker’s
T. delbrueckii strains should serve to encourage attempts to perform similar genetic improvements with wine strains, which is a task that remains to be completed.
With regard to the properties that are desired of yeasts for them to perform industrial alcoholic fermentations efficaciously, the tolerance to high glucose concentrations (up to 700 g/L) of
S. cerevisiae (a poor osmotolerant) was increased by fusing it with the heat-treated protoplasts of an osmotolerant
T. delbrueckii strain. The interspecific hybrids were able to grow in high glucose concentration media, producing enhanced amounts of ethanol. Further investigation of the practical application of these hybrids is pending [
54]. Other than this one-off achievement, there has been little published research related to this issue. In particular, there remains the problem of improving
T. delbrueckii with respect to the properties of
S. cerevisiae that make this latter yeast the best choice for most industrial alcoholic fermentations. It is accepted that
T. delbrueckii may be more resistant than
S. cerevisiae to various stressors such as freeze–thaw or growth in high osmolality media, which can be very important properties for a baker’s yeast used in frozen and frozen sweet dough technology [
52,
53]. While these properties may be interesting for certain specific wine fermentations, there are other stress resistance properties that are generally considered to be of major importance in winemaking technology, such as the resistance to ethanol, SO
2, or Cu, each of which affects the grape must fermentation vigour of
T. delbrueckii.
Based on our experience, some strains of
T. delbrueckii can fully dominate and complete crushed grape fermentation to reach above 14º GL, which is a very high alcohol content for non-
Saccharomyces yeast fermentation (
Figure 4). However, this achievement occurs only rarely, under certain favourable environmental conditions: the presence of only very low amounts of competitor
Saccharomyces yeasts; a very large inoculum of healthy
T. delbrueckii cells to start must fermentation quickly and overcome the growth of any other yeasts; frequent agitation to provide extra oxygen; the addition of some extra amounts of nutrients that are usually contained in crushed grapes but which may be scarce in clarified grape must; low amounts of toxic compounds such as SO
2, Cu, pesticides, etc. Even under these favourable conditions,
T. delbrueckii-dominated fermentation took much longer to complete than
S. cerevisiae-dominated fermentation, because fermentation vigour and cell viability declined more quickly in
T. delbrueckii than in
S. cerevisiae after the wine reached about 5% alcohol (
Figure 4B). The differences in ethanol resistance between the two yeast species can be seen on YEPD agar plates supplemented with different ethanol concentration (
Figure 2). Similarly, while
T. delbrueckii is able to complete fermentation in the presence of 50 mg/L SO
2 (
Figure 5), although a partial lethal effect cannot be ruled out, it is clearly less resistant to this compound than
S. cerevisiae. A concentration of 125 mg/L SO
2, which is frequently used in winemaking, is clearly lethal for
T. delbrueckii (
Figure 2). Moreover, there may be an undesirable amount of Cu in grape juice, because Cu compounds are frequently used as fungicides in the vineyard. Again,
S. cerevisiae is more resistant to Cu than
T. delbrueckii (
Figure 2), meaning that the possible presence of high concentrations (20–30 mg/L) of Cu would reduce fermentation vigour more drastically in the latter yeast than in the former. Experiments to obtain new
T. delbrueckii strains resistant to ethanol, SO
2, and Cu (as well as to high CO
2 pressures) are currently underway to improve the overall fermentation performance of this species of yeast to bring it as close as possible to that usually shown by selected
S. cerevisiae wine yeasts.
A priori, new strains with improved fermentation capacities could be isolated and selected, since there could be intraspecific variations in
T. delbrueckii as they exist in other yeast species such as
S. cerevisiae.